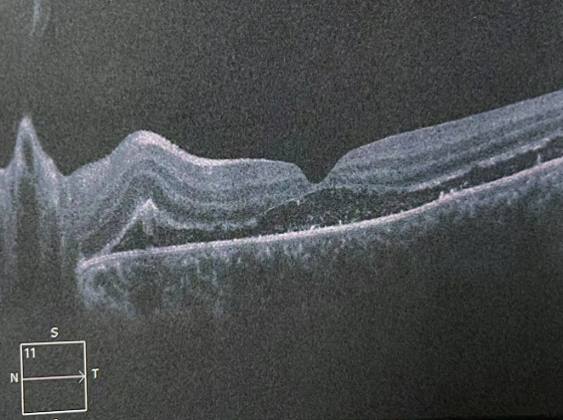

生活是五彩斑斓的,就像我们用眼睛看到的这个世界一样,没错!我们用肉眼看到的世界是五彩缤纷,细节丰富。但想象一下,如果此刻你正在欣赏美景,突然视线的一角开始变得模糊,就像是有人用黑色的笔在视野上戳了一个洞,然后这个“黑洞”逐渐扩大,你的视线被一点点吞噬,直到眼前一片漆黑。这不是电影电视中的特效,而是可能发生在我们生活中的真实威胁——视网膜脱离。
11岁的轩轩是个热爱运动的帅气小男生,一年前左眼被篮球砸伤,出现视物模糊,视力下降,因为担心被父母责骂,并未告知父母,直到体检发现左眼视力下降明显,影响到了自己的生活和学习,在父母的陪同下来到合肥普瑞眼科医院就诊,经检查诊断轩轩为左眼孔源性视网膜脱离。


什么是视网膜脱离?
视网膜,这个名字听起来有些生僻,但它却是我们视觉系统的核心部件。就像一台精密的相机,眼睛捕捉光线,视网膜则负责将这些光线转换成图像,传递给大脑,让我们看到这个世界。视网膜是一层非常薄的膜,但它还可以分为十层结构。其中,靠内侧的九层合起来,叫做神经上皮层,最外面一层叫色素上皮层。我们所说的视网膜脱离,并非是整个视网膜掉下来,而是视网膜内九层与外一层分离了。如果视网膜出现问题,就好比相机的底片受损,图像就会变得模糊不清,甚至完全消失。

好好的视网膜为什么会脱离?
视网膜脱离,属于眼底病的一种类型,会对视力造成严重的影响,严重者可导致患者完全失明。导致视网膜脱落的原因很多,常见的有以下几种:

- 孔源性视网膜脱离
视网膜出现破洞,使眼球内的液体灌入其中而发生剥离。
- 渗出性视网膜脱离
多由其他疾病继发引起,比如妊娠期高血压视网膜病变引起的渗出性视网膜脱离。
- 牵拉性视网膜脱离
多由玻璃体液化、后皮质脱离、增殖牵拉引起。
视网膜脱离的高危人群有哪些?
1.高度近视患者(600度以上)
由于高度近视者【眼轴较长(> 25 mm)】内眼结构发生变化,眼球逐渐扩张变大变长,而与此对应的是,视网膜发育成熟后,其面积是固定的。随着眼球外壁巩膜的扩张,视网膜会被牵拉得越来越薄,继而导致视网膜出现“破洞”。眼睛里的液体就会从“破洞”灌进去,导致视网膜脱离。

高度近视人群发生视网膜脱离的概率是正常人的10倍以上,近视度数越高,脱离的概率越大。
高度近视患者的眼轴比普通眼睛长,眼球比正常人大。随着眼轴拉长,球壁会变薄,周围血管变细,血供差。周围的视网膜组织会出现变性区域和小孔,临床上称为视网膜裂孔。一旦出现裂孔,玻璃体会沿裂孔渗漏到视网膜下,顶起视网膜,使视网膜色素上皮层与神经上皮层分离,出现视网膜脱离,患者出现明显的视野缺损、视力下降等。
2.中老年人
老年人玻璃体大多变性、液化,常伴有各种视网膜变性,因而容易发生视网膜脱落。
3.眼外伤患者
在挫伤中,撞击运动的瞬间可使眼球暂时变形,尽管眼球壁能顺应外力,但玻璃体不能,此时玻璃体基底部与球壁分开,容易产生视网膜锯齿缘离断。
4.患有糖尿病的人群
糖尿病最常见的并发症之一就是眼病,患病时间越长,患者出现视网膜病变的几率越大;糖尿病后期,患者并发的视网膜病变可能造成玻璃体的增值牵拉,导致牵引性视网膜脱离。

- 飞蚊感:眼前突然出现许多飘动的黑影
- 闪光感:出现光斑、光点,一般出现在视野的边缘
- 视野遮挡:眼前出现如同幕布或窗帘样的黑影遮挡,黑影可以静止不动,也可以逐渐扩大。
- 视物变形,视力下降:部分慢性视网膜脱离的患者会出现视物变形,缓慢的视力下降等,部分可伴有玻璃体出血等。
视网膜脱离如何治疗
- 预防治疗
如果能早期发现视网膜裂孔,尚无视网膜脱离,应该及早使用激光封闭裂孔,防止进一步发展为视网膜脱离。
- 手术治疗
已经发生视网膜脱离的患者需要手术治疗。手术可以根据视网膜裂孔的位置、数目,大小,视网膜脱离的范围,时间,视网膜周围有无牵拉及玻璃体液化的程度分为内路和外路手术。内路手术主要是玻璃体切割术联合视网膜复位手术及激光光凝术,是从眼球内进行手术。外路手术主要是巩膜外压术和巩膜环扎术,从巩膜外进行手术,不进入眼球内部。

来源:推广



评论